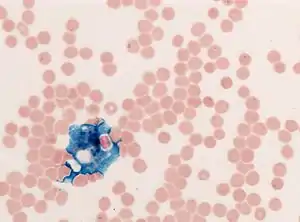

Perls Prussian blue
In histology, histopathology, and clinical pathology, Perls Prussian blue is a commonly used method to detect the presence of iron in tissue or cell samples.[1]: 235 [2][3][4] Perls Prussian Blue derives its name from the German pathologist Max Perls (1843–1881), who described the technique in 1867.[2] The method does not involve the application of a dye, but rather causes the pigment Prussian blue to form directly within the tissue.[5] The method stains mostly iron in the ferric state which includes ferritin and hemosiderin, rather than iron in the ferrous state.[6]
Uses

Perls's method is used to indicate "non-heme" iron in tissues such as ferritin and hemosiderin,[6] the procedure does not stain iron that is bound to porphyrin forming heme such as hemoglobin and myoglobin.[2] The stain is an important histochemical stain used to demonstrate the distribution and amount of iron deposits in liver tissue, often in the form of a biopsy.[6][7] Perls's procedure may be used to identify excess iron deposits such as hemosiderin deposits (hemosiderosis) and in conditions such as hereditary hemochromatosis.[8] Perls Prussian blue is commonly used on bone marrow aspirates to indicate levels of iron storage[4] and may provide reliable evidence of iron deficiency.[7]
Method of application

Perls did not publish a detailed procedure other than indicating a dilute potassium ferrocyanide solution was applied to the tissue followed by hydrochloric acid.[2] Ferric iron deposits in tissue (present mostly as ferric iron within the storage protein ferritin) then react with the soluble ferrocyanide in the stain to form the insoluble Prussian blue pigment (a complex hydrated ferric ferrocyanide substance). These deposits are then visualizable microscopically as blue or purple deposits.[9]
Many methods of performing Perls Prussian blue stain for iron have been published, [2] Drury and Wallington (1980) give a protocol that uses a mixture of 1 part 2% hydrochloric acid and 1 part 2% potassium ferrocyanide that is applied to the section for 20–30 minutes followed by a rinse in distilled water and application of a counterstain such as eosin, safranin or neutral red.[5]
Mode of action

Potassium ferrocyanide in the staining solution combines with the ferric iron forming the Prussian blue pigment.[5][2] The addition of hydrochloric acid increases the availability of iron within the tissue for reaction with the potassium ferrocyanide.[2] The chemical reaction for the conversion of iron to Prussian blue is provided as follows in Drury and Wallington[5] (1980):
4FeCl3 + 3K4Fe(CN)6 → Fe4[Fe(CN)6]3 + 12KCl
(ferric iron) + (potassium ferrocyanide) → (ferric ferrocyanide or Prussian blue)
References
- ↑ Bancroft, John; Stevens, Alan, eds. (2008). The Theory and Practice of Histological Techniques (2nd ed.). Longman Group Limited. ISBN 9780443102790. OCLC 1057997222.
- 1 2 3 4 5 6 7 Meguro, Reiko; Asano, Yoshiya; Odagiri, Saori; et al. (2007). "Nonheme-iron histochemistry for light and electron microscopy: a historical, theoretical and technical review". Archives of Histology and Cytology. 70 (1): 1–19. doi:10.1679/aohc.70.1. ISSN 0914-9465. PMID 17558140.
- ↑ Parmley, R T; Spicer, S S; Alvarez, C J (1978). "Ultrastructural localization of nonheme cellular iron with ferrocyanide". Journal of Histochemistry & Cytochemistry. 26 (9): 729–741. doi:10.1177/26.9.712049. ISSN 0022-1554. PMID 712049.
- 1 2 Theil, Karl S. (2012). "Bone Marrow Processing and Normal Morphology". Laboratory Hematology Practice. pp. 279–299. doi:10.1002/9781444398595.ch22. ISBN 9781444398595.
- 1 2 3 4 Drury, R. A. B.; Wallington, E. A. (1980). Carleton's Histological Technique (5th ed.). Oxford University Press. p. 520. ISBN 0-19-261310-3.
- 1 2 3 Iezzoni, Julia C. (2018). "Diagnostic histochemistry in hepatic pathology". Seminars in Diagnostic Pathology. 35 (6): 381–389. doi:10.1053/j.semdp.2018.10.003. PMID 30409459.
- 1 2 Garcia-Casal, Maria N; Pasricha, Sant-Rayn; Martinez, Ricardo X; et al. (2015). "Serum or plasma ferritin concentration as an index of iron deficiency and overload". Cochrane Database of Systematic Reviews. doi:10.1002/14651858.CD011817.
- ↑ Kumar, Vinay; Abbas, Abul K.; Aster, Jon C. (2013). Robbins basic pathology (9th ed.). Elsevier/Saunders. p. 910. ISBN 978-1-4377-1781-5.
- ↑ dreyngerous. "Perl'S / Prussian Blue Staining: stained films of marrow and blood. The formalin". Scribd. Retrieved April 2, 2009.